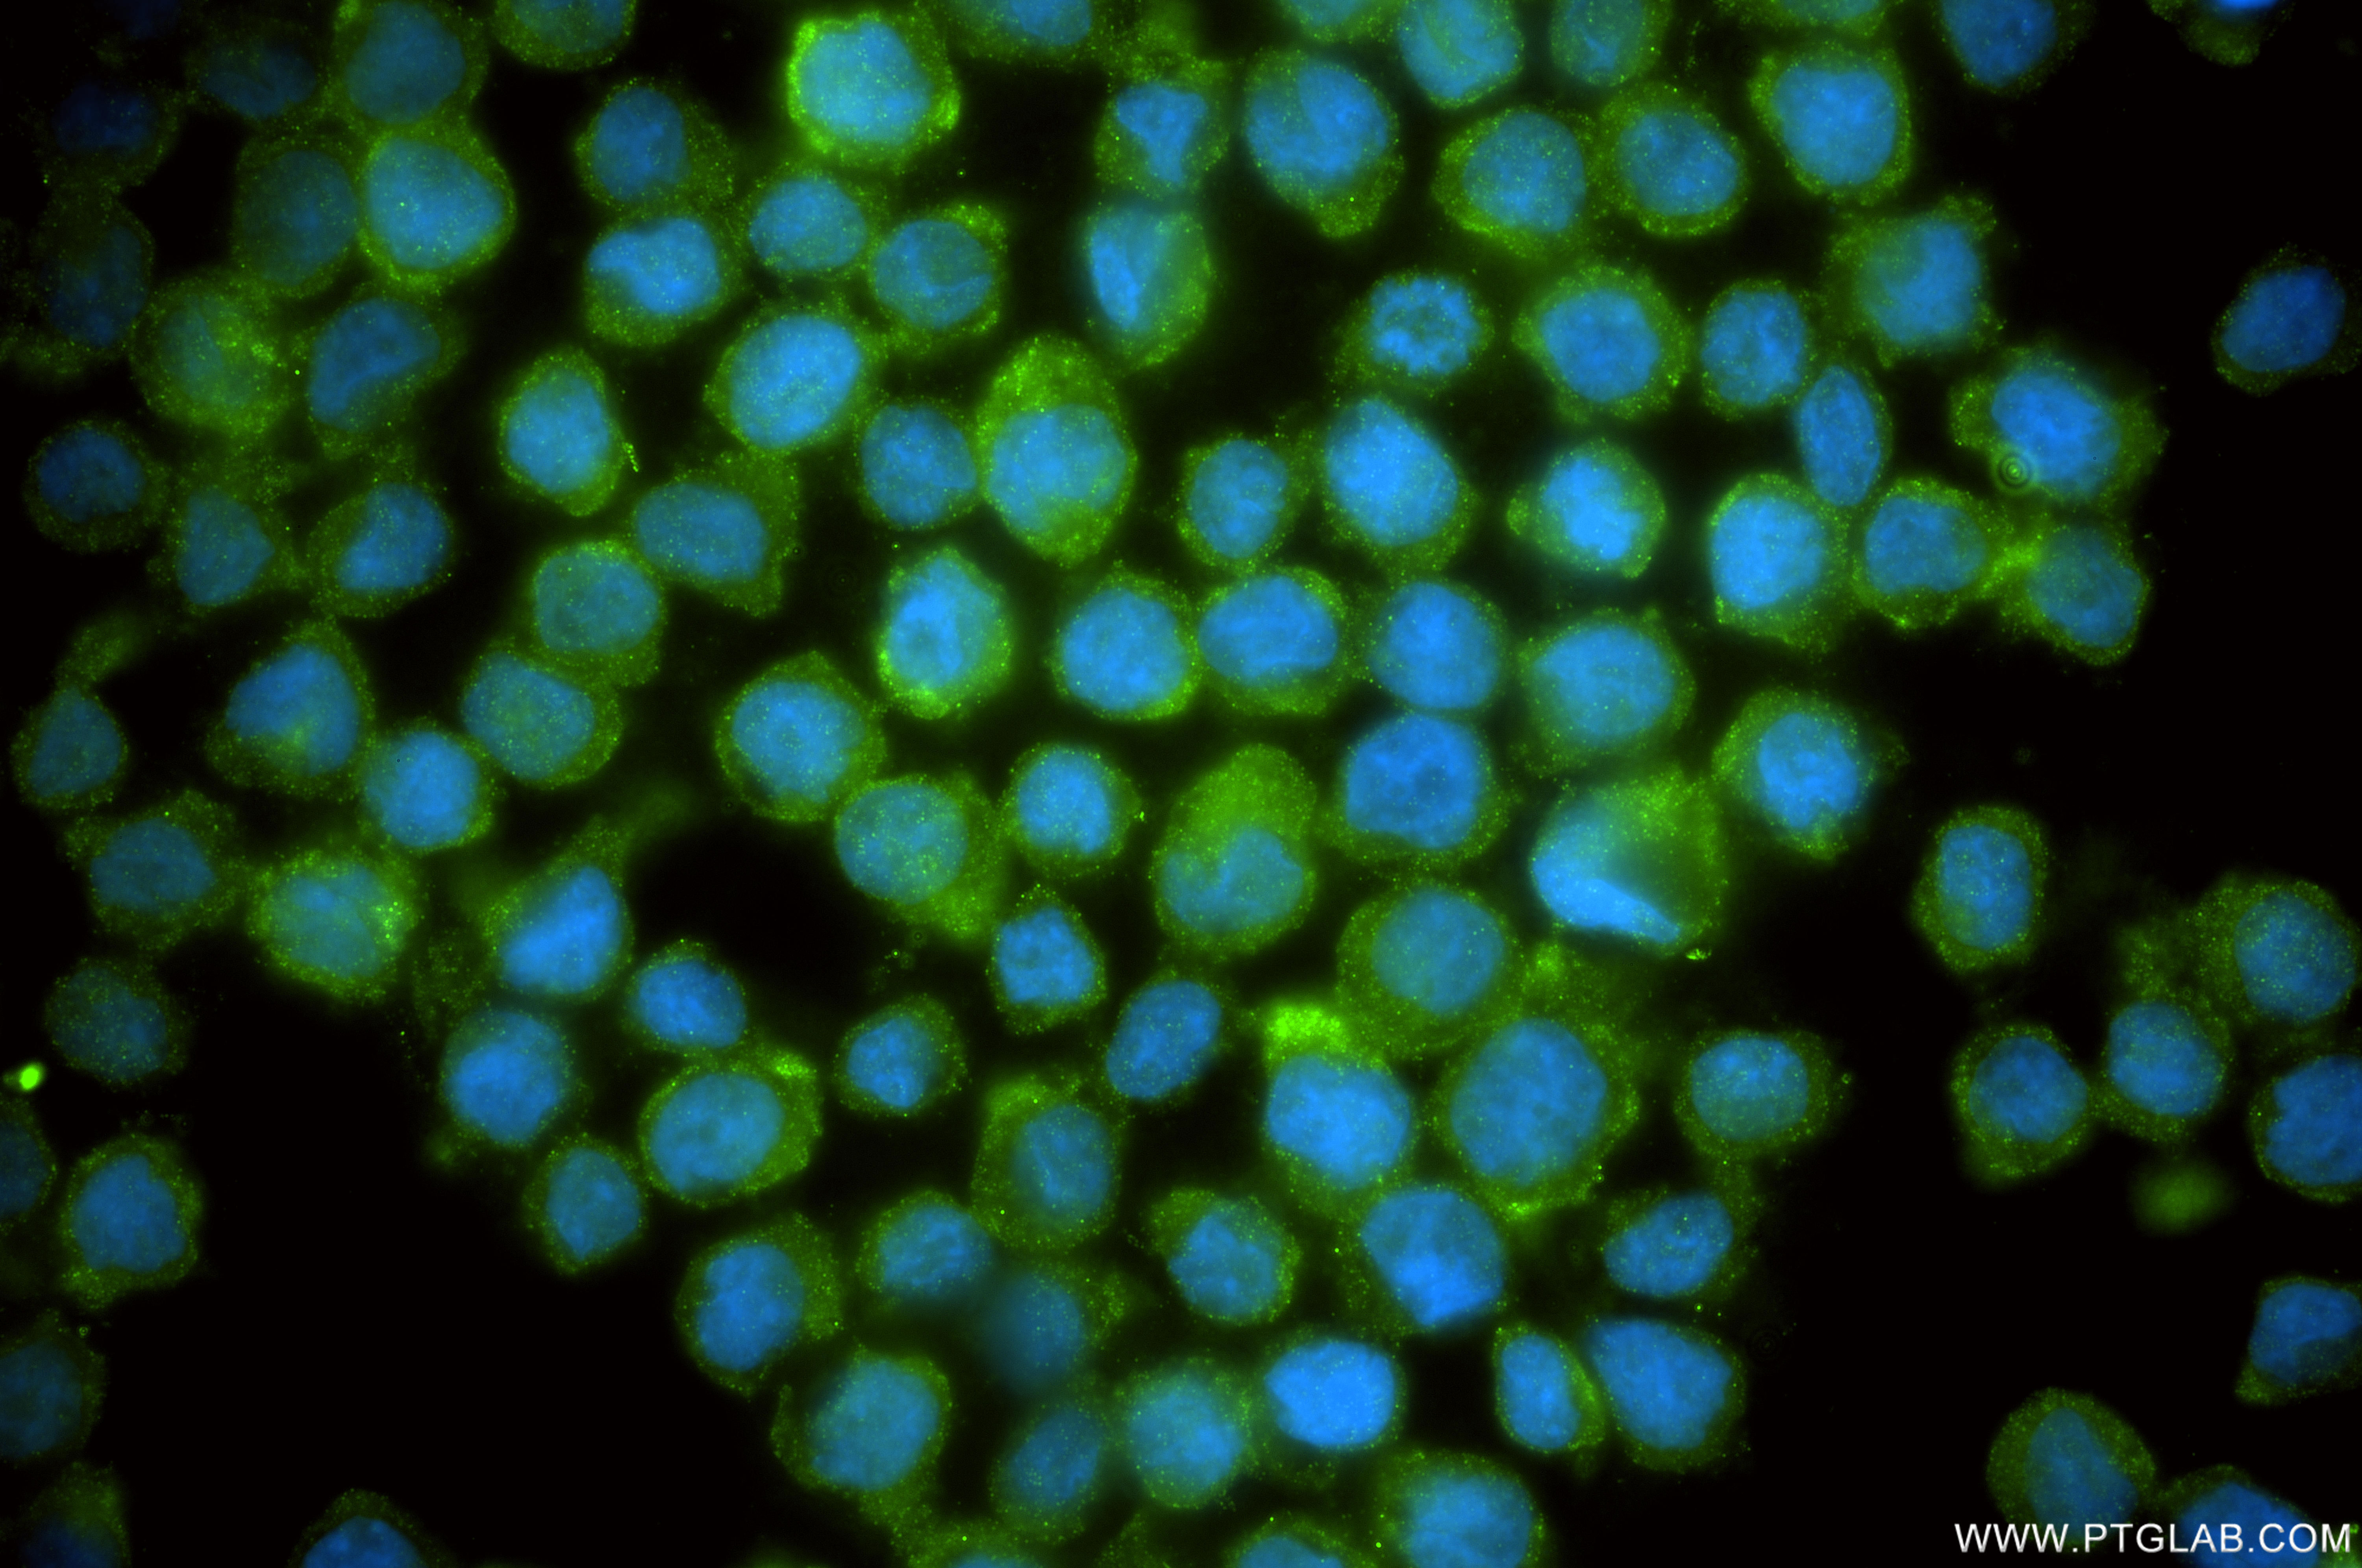
Immunofluorescent analysis of (4% PFA) fixed THP-1 cells using MCOLN2 antibody (<a class='green' href='/productredirect?CatalogNo=98650-1-RR' target='_blank'>98650-1-RR</a>, Clone: 251091D10 ) at dilution of 1:200 and CoraLite®488-Conjugated Goat Anti-Rabbit IgG(H+L) (<a class='green' href='/productredirect?CatalogNo=SA00013-2' target='_blank'>SA00013-2</a>). This data was developed using the same antibody clone with 98650-1-PBS in a different storage buffer formulation. IF Staining of THP-1 using 98650-1-RR (same clone as 98650-1-PBS)

验证数据展示
产品信息
98650-1-PBS targets MCOLN2 in IF/ICC, FC applications and shows reactivity with human samples.
| 经测试应用 | IF/ICC, FC Application Description |
| 经测试反应性 | human |
| 免疫原 |
Peptide 种属同源性预测 |
| 宿主/亚型 | Rabbit / IgG |
| 抗体类别 | Recombinant |
| 产品类型 | Antibody |
| 全称 | mucolipin 2 |
| 别名 | mucolipin 2, Mucolipin-2, Transient receptor potential channel mucolipin 2, TRP ML2, TRPML2 |
| 计算分子量 | 566 aa, 66 kDa |
| GenBank蛋白编号 | BC104891 |
| 基因名称 | MCOLN2 |
| Gene ID (NCBI) | 255231 |
| RRID | AB_3746247 |
| 偶联类型 | Unconjugated |
| 形式 | Liquid |
| 纯化方式 | Protein A purification |
| UNIPROT ID | Q8IZK6 |
| 储存缓冲液 | PBS only, pH 7.3. |
| 储存条件 | Store at -80°C. The product is shipped with ice packs. Upon receipt, store it immediately at -80°C |
背景介绍
MCOLN2 (Mucolipin-2), also known as TRPML2, is a member of the transient receptor potential mucolipin (TRPML) family of gated cation channels. Primarily localized in the membranes of endosomes and lysosomes, it plays critical roles in intracellular trafficking, immune responses, and disease progression